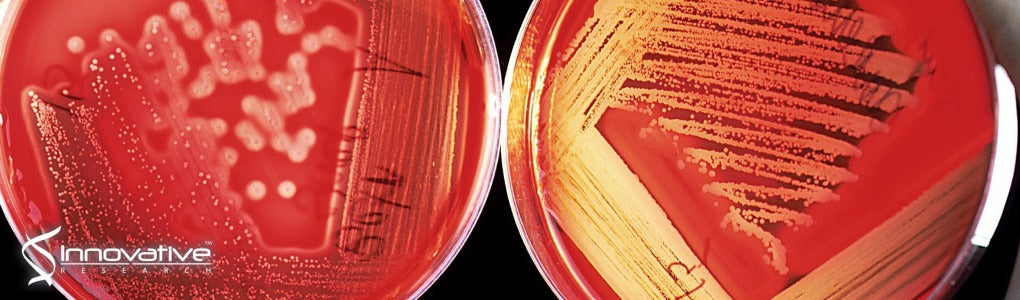
LC-MS/MS Method for Simultaneous Quantification of the First-Line Anti-Tuberculosis Drugs and Six Primary Metabolites in Patient Plasma: Implications for Therapeutic Drug Monitoring

Single Donor Human Plasma (Blood Derived) from Innovative Research was used in the following study:
Agnija Kivrane, Solveiga Grinberga, Eduards Sevostjanovs, Viktorija Igumnova, Ilva Pole, Anda Viksna, Dace Bandere, Alvils Krams, Andra Cirule, Osvalds Pugovics, Renate Ranka
Journal of Chromatography B
November 15, 2021
Tuberculosis (TB) is an infection caused by an airborne bacteria called Mycobacterium tuberculosis. Despite the advances in treating TB over the years there is still an estimated 10 million new cases around the world annually, and roughly 15% of these patients experience a drug resistant form of the disease or will relapse into infection following normal treatment.
Pharmacokinetic profiling of drugs and their metabolites via observation in the biological matrix is one of the best tools available for gathering information regarding treatment efficacy. In this study, researchers developed a liquid chromatography-tandem mass spectrometry (LC-MS/MS) method for monitoring common TB drugs and their metabolites in human plasma.
Related products available from Innovative Research also include:
Pooled Human Serum Off The Clot